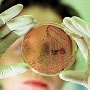
В одном из хозяйств Воронежской области выявлен очаг бруцеллеза

Новости отрасли

|
В одном из хозяйств Воронежской области выявлен очаг бруцеллеза
В крестьянско-фермерском хозяйстве Новоусманского района выявлен очаг заболевания крупного рогатого скота бруцеллезом
Заболевание зафиксировано в хозяйстве индивидуального предпринимателя Броян С.В. (Воронежская обл., Новоусманский район, с. Хреновое). По уточненным данным численность поголовья в хозяйстве составляет 533 головы.
В ходе проведения эпизоотологического расследования установлено, что в конце прошлого месяца года в хозяйстве начались аборты на поздних сроках стельности.
При исследовании 3-х абортируемых плодов в марте текущего года в БУВО «Воронежская областная ветеринарная лаборатория», а также на основании клинических признаков, подозрение на заболевание животных бруцеллезом подтвердилось.
В настоящее время Указом губернатора Воронежской области от 14.03.2013 г. на территории хозяйства ИП глава К(Ф)Х Броян С.В установлены ограничения по заболеванию бруцеллезом крупного рогатого скота. Запрещен вывоз молока за пределы хозяйства, ввоз на территорию хозяйства и вывоз из него восприимчивых к бруцеллезу животных, а также перегруппировка животных внутри хозяйства без разрешения руководителя БУВО «Новоусманская райСББЖ».
В соответствии с ветеринарными санитарными правилами «Профилактика и борьба с заразными болезнями, общими для человека и животных» БРУЦЕЛЛЕЗ (СП 3.1.7.2613-10, ВП 13.3.1302-96), разрабатывается план организационно-хозяйственных и ветеринарно-санитарных мероприятий по оздоровлению неблагополучного пункта по бруцеллезу.
Необходимо отметить, что заболевание бруцеллезом среди крупного рогатого скота в Новоусманском районе было зафиксировано в 1960 году в частном секторе населенных пунктов Парусное и Безбожник (по одной голове), а также в 1964 году – среди свиней в колхозе «Большевик» в с. Каширское (224 головы), среди лошадей в колхозе «Ленинский путь» в с. Новая Усмань (одна голова).
На протяжении последних десятилетий Воронежская область является стационарно благополучной по бруцеллезу, однако опасное заболевание возникло в связи бесконтрольным ввозом инфицированных животных на территорию субъекта.
Управление Россельхознадзора обращает внимание хозяйствующих субъектов и граждан: с целью недопущения возникновения и распространения бруцеллеза ввоз животных нужно производить с эпизоотически благополучной территории при согласовании в обязательном порядке с госветслужбой субъекта. При ввозе животные должны пройти 30-дневный период карантинирования, в течение которого проводятся все необходимые клинические мероприятия и диагностические исследования.
Бруцеллез, мальтийская лихорадка, болезнь Банга, общее острое или хронически протекающее инфекционно-аллергическое заболевание человека и животных. Характеризуется многообразием клинических проявлений, длительностью течения, поражениями нервной системы, костей и суставов.
Бруцеллез распространён почти во всех странах мира и наносит большой экономический ущерб животноводству.


